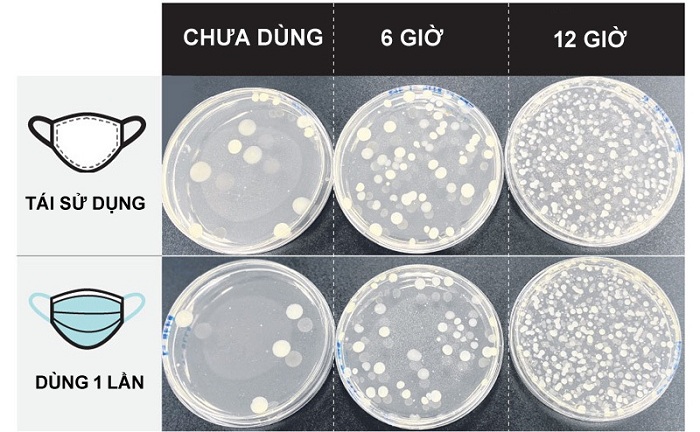

Dùng khẩu trang như thế nào là tốt nhất?
(SK&MT) - Các nghiên cứu đã lưu ý rằng khẩu trang được đeo nhiều lần, trong thời gian dài cần được giặt thường xuyên vì chúng chứa vi khuẩn từ da và các giọt bắn từ đường hô hấp. Môi trường ấm và ẩm trong các loại khẩu trang có lợi cho vi sinh vật phát triển. Tuy nhiên, không phải mọi vi khuẩn đều gây hại.
Lượng vi khuẩn trên khẩu trang sau 6 và 12 giờ sử dụng
Phòng thí nghiệm Eurofins tìm thấy lượng lớn vi khuẩn, nấm mốc trong khẩu trang của những người tham gia khảo sát. Thử nghiệm sử dụng khẩu trang dùng một lần và tái sử dụng được đeo trong 6 giờ và 12 giờ nhằm mục đích so sánh.
Sau đó, các nhà khoa học kiểm tra tổng số vi khuẩn, nấm mốc, cũng như vi khuẩn tụ cầu liên quan đến nhiễm trùng da và trực khuẩn mủ xanh liên quan đến phát ban có trong khẩu trang.
Vi khuẩn tụ cầu và trực khuẩn mủ xanh không có trong bất kỳ mẫu khẩu trang nào. Lượng nấm mốc và vi khuẩn ở khẩu trang đã đeo trong 12 giờ cao hơn hẳn loại 6 giờ.
Giới chuyên môn lý giải môi trường ấm và ẩm trong tất cả các loại khẩu trang có lợi cho vi sinh vật phát triển. Nhưng họ lưu ý rằng không phải tất cả các vi sinh vật đều có hại.
Giáo sư William Chen, Giám đốc chương trình Khoa học và Công nghệ Thực phẩm của Đại học Công nghệ Nanyang (Singapore), cho biết: “Trong môi trường bao quanh chúng ta đều có vi khuẩn, trong hệ tiêu hóa (miệng và ruột) cũng vậy. Bởi thế, không có gì lạ khi tìm thấy vi khuẩn trên khẩu trang".
Các cuộc nghiên cứu sâu hơn sẽ xác định loại vi khuẩn trên khẩu trang liệu có khả năng gây bệnh hay không.
Tiến sĩ Joel Lee, Hiệu trưởng Trường Khoa học Hóa học và Đời sống thuộc Đại học Bách khoa Nanyang, cho biết chất liệu của khẩu trang liên quan tới việc tích tụ vi khuẩn. Ông lưu ý sự khác biệt chính giữa khẩu trang dùng một lần và tái sử dụng là chất liệu của lớp bên trong gần với miệng nhất. "Lớp bên trong này rất có thể là nơi vi khuẩn bị giữ lại khi bạn ho, hắt hơi hoặc chúng có thể được phun thành giọt khi chúng ta nói chuyện", Tiến sĩ Lee nói.
Trong khẩu trang tái sử dụng được đeo trong 6 giờ và không giặt trong một tuần có dấu vết của vi khuẩn, nấm mốc.
Tiến sĩ Lee cho biết, khẩu trang không được giặt sạch thường xuyên có thể bám bụi, bẩn, mồ hôi và nhiều loại vi khuẩn khác. Điều này có nguy cơ gây ra mẫn cảm, kích ứng da hoặc nhiễm trùng.
Tiến sĩ John Chen, Trường Y Yong Loo Lin, Đại học Quốc gia Singapore, cho biết vi khuẩn trên khẩu trang không dẫn đến điều gì đó nghiêm trọng trong đại đa số các trường hợp.
Tuy nhiên, một số vi khuẩn cư trú trên da khỏe mạnh có thể phát triển quá mức trên khẩu trang bẩn và gây bệnh. Tiến sĩ Chen cho biết: “Ở mức độ thấp, hệ miễn dịch của bạn luôn kiểm soát chúng, nhưng ở mức độ cao, chúng có thể gây ra dị ứng từ nhẹ đến nặng, các vấn đề về hô hấp và thậm chí là nhiễm trùng mũi”.
Vì rất khó để xác định liệu có vi khuẩn có hại trên khẩu trang hay không, Tiến sĩ Chen khuyên mọi người nên giặt khẩu trang thường xuyên hoặc sau mỗi lần sử dụng nếu có thể.
Linh Đức
Các tin khác
Báo chí VUSTA phát huy vai trò kết nối trí thức, kiến tạo niềm tin và khơi dậy khát vọng đổi mới sáng tạo
Hội thảo khoa học: Ứng dụng công cụ AI trong phát triển giáo dục nghề nghiệp
Hội thảo “Xây dựng và phát triển tủ sách Khoa học và Công nghệ”
Tổng Bí thư chỉ rõ 'chìa khóa vàng' cho khát vọng Việt Nam hùng cường, thịnh vượng
Tâm huyết, trí tuệ của cử tri trí thức Liên hiệp các Hội KHKT Việt Nam trước kỳ họp thứ 10 Quốc hội khóa XV
“Thiết kế điện tử Việt Nam 2025” – một cuộc tranh tài công nghệ AIOT lớn nhất Việt Nam
Báo chí với vai trò kiến tạo hệ sinh thái khoa học – công nghệ
Báo chí, truyền thông đóng vai trò đặc biệt quan trọng trong công tác phòng, chống thiên tai
Quốc hội không ngừng phát triển, xây dựng vị thế vững chắc trong lòng nhân dân
Đọc nhiều
Chiếc thẻ và cơn gió ngược của nghề báo
Khi Bí thư xã làm “Đại sứ OCOP” ở xã Tân Hòa, TP. Cần Thơ
Khẩn trương triển khai dự án Nhà máy điện mặt trời Sao Mai 1 tại Cần Thơ
Tự xưng "Phòng khám Thẩm mỹ Nội khoa", DMANH Beauty bị Sở Y tế Hà Nội “chỉ mặt” hoạt động không phép
Phú Thọ: Công ty xử lý môi trường bị xử phạt hơn 172 triệu đồng vì gây ô nhiễm môi trường
Videos
E-magazine Inforgraphic Video
Xã Ô Diên – Hà Nội: Bất cập từ bãi vật liệu xây dựng gây ô nhiễm môi trường và trách nhiệm quản lý tại địa bàn cơ sở
Cảnh báo hành vi giả danh cán bộ thuế, cơ quan thuế để lừa đảo
Phòng ngừa cháy nổ trong dịp Tết Nguyên đán
Bản tin tổng hợp số 8 tháng 11 của Tạp chí Sức khoẻ & Môi trường
Hà Nội (Q.Hà Đông) : Môi trường sống của người dân không được đảm bảo bởi những công trình vi phạm TTXD
Giải pháp giảm thiểu đốt ngoài trời, sử dụng thuốc bảo vệ thực vật trong nông nghiệp - Cơ hội từ GAHP
Ngành Thép hướng tới tiêu hao nguyên liệu thấp
Chính thức thông cầu phao tạm thay thế cầu Phong Châu (Phú Thọ)
Cách xử lý vệ sinh môi trường sau mùa bão lụt
Tuần lễ Khoa học công nghệ, Đổi mới sáng tạo và Chuyển đổi số thành phố Cần Thơ
Cô gái Khmer tiên phong đưa đường thốt nốt An Giang xuất ngoại
Đổi mới sáng tạo khẳng định vị thế của nông nghiệp Việt Nam
Nghệ nhân Lê Nguyễn Hoàng Anh Duy - người sáng lập thương hiệu đồng hồ MarkLE
Chủ tịch Quốc hội Trần Thanh Mẫn: Đặt lợi ích người dân làm trung tâm trong công tác quy hoạch
Du lịch nâng tầm giá trị làng nghề, hướng tới mô hình phát triển bền vững
HUBT thành lập Hội đồng trường theo Luật Giáo dục đại học
Herbalife Việt Nam được trao giải thưởngTrách Nhiệm Xã Hội Doanh Nghiệp của AmCham lần thứ tám liên tiếp
Siêu ngày đôi 12/12, săn vé siêu khuyến mãi giảm giá 100% cùng Vietjet
Tập đoàn BRG lần thứ 5 liên tiếp được vinh danh doanh nghiệp bền vững Việt Nam
Để “Mộc Dương Quang” nổi danh góp phần làm tăng uy tín và giá trị của sản phẩm
Vietjet đón 22 tàu bay mới trong dịp Noel, tiếp tục bứt phá với đội tàu hàng đầu khu vực
Thủ tướng đề xuất 3 ưu tiên chiến lược cho 3 chuyển động lớn của thế giới
Nhiều chương trình hấp dẫn đón Xuân Ất Tỵ tại Cantho Eco Resort
Trung Quốc: Số ca mắc bệnh lý đường hô hấp tiếp tục tăng
Báo động tỷ lệ nhiễm HIV ở phụ nữ và trẻ em gái
Nước hoa, mỹ phẩm cao cấp UNI: Tinh hoa từ Trầm Hương Việt
Bác sĩ Trần Nguyên Giáp: Chuyện “dính phốt” của một người quá mát tay trong ngành thẩm mỹ
Hành trình 13 năm xây dựng thương hiệu Thẩm mỹ Vũ Quang
Bác sĩ Nguyễn Hải Đăng: “Kiến tạo nụ cười, mang đến hạnh phúc”
Nâng cao nhận thức tạo chuyển động xã hội thực hiện Nghị quyết 57/NQTW
Trí thức Việt Nam đồng hành vì một tương lai xanh
Tuần lễ Khoa học công nghệ, Đổi mới sáng tạo và Chuyển đổi số thành phố Cần Thơ